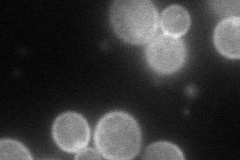
YHL026C
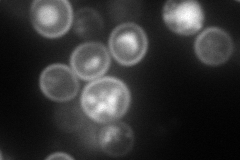
YHL026C
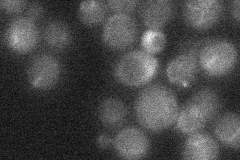
YHL026C
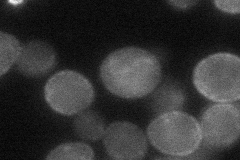
YHL026C

View description
Putative protein of unknown function; YHL026C is not an essential gene; in 2005 the start site was moved 141 nt upstream (see Locus History)
Localization:
Intensity:
Fold change:
Significance:
-
C’ GFP library in SD

below threshold18.74 -
N' NOP1pr-GFP in SD
cell periphery72.2659 -
N' TEF2pr-mCherry in SD
cell periphery,vacuole162.805 -
N' NATIVEpr-GFP in SD
below threshold18.4495 -
N' TEF2pr-VC and Cyto-VN in SD
cell periphery38.8506 -
C’ GFP library in SD+DTT

cytosol14.390.76No -
C’ GFP library in SD+H2O2

cytosol17.30.92No -
C’ GFP library in Starvation Media

cytosol16.970.9No -
C’ GFP library on the background of Pup2-DaMP

N/A -
C’ GFP library on the background of CCT mutant

N/A0N/AYes
